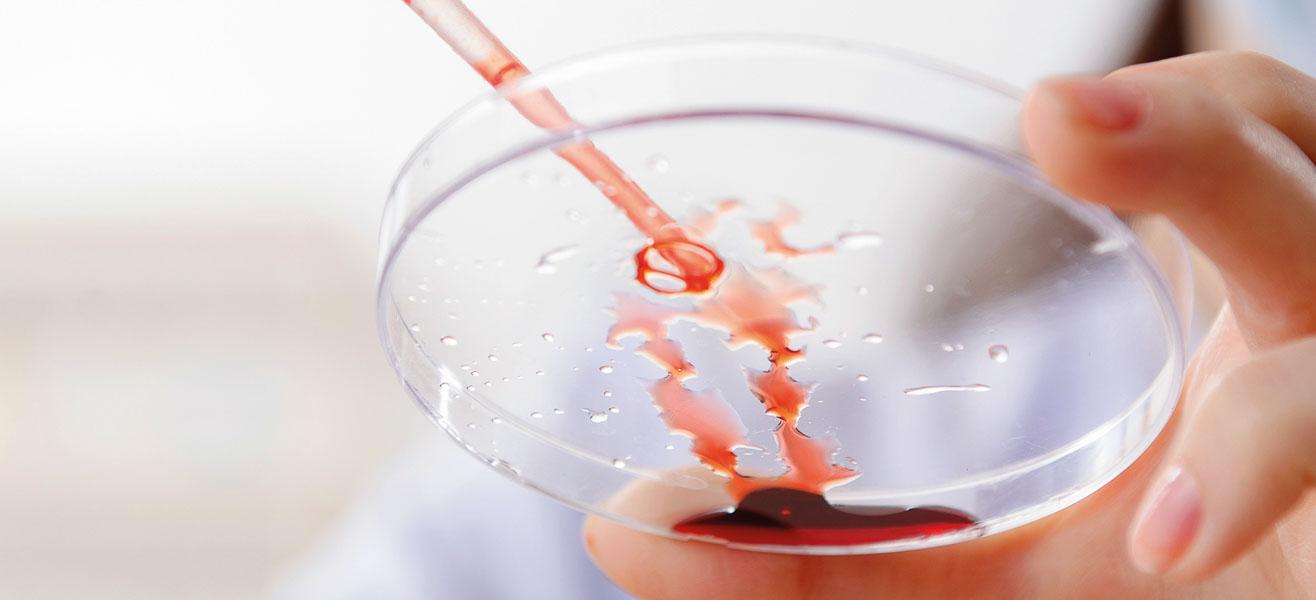

Nieuwe onderzoeksvoorstellen: Oproep aan onderzoekers.

Hematon Onderzoeksfonds financiert jaarlijks wetenschappelijk onderzoek op het gebied van de hematologie. Voor komend jaar zijn dat drie onderzoeken. Dankzij een donatie-actie van een Hematon-lid en dankzij de familie van een patiënt zijn er twee extra onderzoeken mogelijk gemaakt. De aanvraag moet vóór 1 december 2025 worden ingezonden.
De oproep aan onderzoekers is recent verstuurd naar alle leden van de Nederlandse Vereniging voor Hematologie. Onderzoekers worden opgeroepen een aanvraag te doen voor financiering van onderzoek op het gebied van hemato-oncologische aandoeningen.
Er is geld beschikbaar om drie onderzoeksvoorstellen te honoreren: één voor onderzoek op het gebied van multipel myeloom en de ziekte van Waldenström, één voor de overige hemato-oncologische aandoeningen en één specifiek voor onderzoek naar folliculair lymfoom. De maximale vergoeding is € 50.000 per onderzoek, dat eventueel over meerdere jaren wordt uitgesmeerd.
